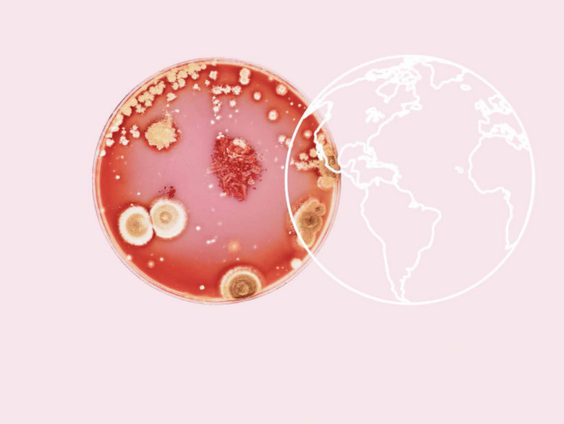
'Antibioticaresistentie vormt groot gevaar voor volksgezondheid'

Uitzending gemist
NOS Radio 1 Journaal
- Gids
- NOS Radio 1 Journaal
Gepresenteerd door: Astrid Kersseboom
Elke ochtend tussen 06:00 en 09:30 uur: het NOS Radio 1 Journaal. In de uitzendingen komen het laatste nieuws, achtergronden, reacties, analyses en sport aan bod.